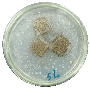
Jcs 07 00512 i006

Utilization of Spent Coffee Grounds as a Sustainable Resource for the Synthesis of Bioplastic Composites with Polylactic Acid, Starch, and Sucrose
Abstract
:1. Introduction
2. Materials and Methods
2.1. Materials
2.2. Development of Bioplastic Composites
2.3. FTIR Analysis
2.4. Thermal Properties Analysis
2.5. Water Vapor Transmission Rate (WVTR) and Water Vapor Permeable (WVP) Analysis
2.6. Mechanical Strength Analysis
2.7. X-ray Diffraction
2.8. FESEM Analysis
2.9. Biodegradability Analysis
3. Results and Discussion
3.1. FTIR Spectra
3.2. Thermal Analysis
3.3. WVTR and WVP
3.4. Mechanical Properties
3.5. Morphology of SPT Bioplastic
3.6. X-ray Diffraction (XRD)
3.7. Biodegradability
4. Conclusions
Author Contributions
Funding
Data Availability Statement
Acknowledgments
Conflicts of Interest
References
- Shaik, S.A.; Schuster, J.; Shaik, Y.P.; Kazmi, M. Manufacturing of Biocomposites for Domestic Applications Using Bio-Based Filler Materials. J. Compos. Sci. 2022, 6, 78. [Google Scholar] [CrossRef]
- Mastalygina, E.E.; Olkhov, A.A.; Vorontsov, N.V.; Kiselev, N.V.; Khaidarov, T.B.; Khaydarov, B.B.; Kolesnikov, E.A.; Burmistrov, I.N. Influence of Copper-Based Fillers on Structural and Mechanical Properties of Polylactic Acid Composites. J. Compos. Sci. 2022, 6, 386. [Google Scholar] [CrossRef]
- Zubir, N.H.M.; Sam, S.T.; Zulkepli, N.N.; Omar, M.F. The Effect of Rice Straw Particulate Loading and Polyethylene Glycol as Plasticizer on the Properties of Polylactic Acid/Polyhydroxybutyrate-Valerate Blends. Polym. Bull. 2018, 75, 61–76. [Google Scholar] [CrossRef]
- DeStefano, V.; Khan, S.; Tabada, A. Applications of PLA in Modern Medicine. Eng. Regen. 2020, 1, 76–87. [Google Scholar] [CrossRef]
- Wang, N.; Yu, J.; Chang, P.R.; Ma, X. Influence of Citric Acid on the Properties of Glycerol-Plasticized Dry Starch (DTPS) and DTPS/Poly(Lactic Acid) Blends. Starch-Stärke 2007, 59, 409–417. [Google Scholar] [CrossRef]
- Kusumaningrum, W.B.; Syamani, F.A.; Suryanegara, L. Heat Properties of Polylactic Acid Biocomposites after Addition of Plasticizers and Oil Palm Frond Microfiber. J. Kim. Sains Dan Apl. 2020, 23, 295–304. [Google Scholar] [CrossRef]
- Wuk Park, J.U.N.; Soon, S.I.; Kim, H.; Kim, Y.H. Biodegradable Polymer Blends of Poly(L-Lactic Acid) and Gelatinized Starch. Polym. Eng. Sci. 2000, 40, 2539–2550. [Google Scholar] [CrossRef]
- Shahavi, M.H.; Selakjani, P.P.; Abatari, M.N.; Antov, P.; Savov, V. Novel Biodegradable Poly (Lactic Acid)/Wood Leachate Composites: Investigation of Antibacterial, Mechanical, Morphological, and Thermal Properties. Polymers 2022, 14, 1227. [Google Scholar] [CrossRef]
- Martinez Villadiego, K.; Arias Tapia, M.J.; Useche, J.; Escobar Macías, D. Thermoplastic Starch (TPS)/Polylactic Acid (PLA) Blending Methodologies: A Review. J. Polym. Environ. 2022, 30, 75–91. [Google Scholar] [CrossRef]
- Kaseem, M.; Hamad, K.; Deri, F. Thermoplastic Starch Blends: A Review of Recent Works. Polym. Sci. Ser. A 2012, 54, 165–176. [Google Scholar] [CrossRef]
- Yu, W.; Yuan, T.; Yao, Y.; Deng, Y.; Wang, X. PLA/Coffee Grounds Composite for 3D Printing and Its Properties. Forests 2023, 14, 367. [Google Scholar] [CrossRef]
- Wang, N.; Yu, J.; Chang, P.R.; Ma, X. Influence of Formamide and Water on the Properties of Thermoplastic Starch/Poly(Lactic Acid) Blends. Carbohydr. Polym. 2008, 71, 109–118. [Google Scholar] [CrossRef]
- Moustafa, H.; Guizani, C.; Dufresne, A. Sustainable Biodegradable Coffee Grounds Filler and Its Effect on the Hydrophobicity, Mechanical and Thermal Properties of Biodegradable PBAT Composites. J. Appl. Polym. Sci. 2017, 134, 1–11. [Google Scholar] [CrossRef]
- Karmee, S.K. A Spent Coffee Grounds Based Biorefinery for the Production of Biofuels, Biopolymers, Antioxidants and Biocomposites. Waste Manag. 2018, 72, 240–254. [Google Scholar] [CrossRef] [PubMed]
- Atabani, A.E.; Al-Muhtaseb, A.H.; Kumar, G.; Saratale, G.D.; Aslam, M.; Khan, H.A.; Said, Z.; Mahmoud, E. Valorization of Spent Coffee Grounds into Biofuels and Value-Added Products: Pathway towards Integrated Bio-Refinery. Fuel 2019, 254, 115640. [Google Scholar] [CrossRef]
- Mak, S.L.; Wu, M.Y.T.; Chak, W.Y.; Kwong, W.K.; Tang, W.F.; Li, C.H.; Lee, C.C.; Li, C.Y. A Feasibility Study on Making Polylactic Acid (PLA) Polymers by Using Spent Coffee Ground. Sustainability 2023, 15, 13498. [Google Scholar] [CrossRef]
- Talalaj, I.A.; Biedka, P. Use of the Landfill Water Pollution Index (LWPI) for Groundwater Quality Assessment near the Landfill Sites. Environ. Sci. Pollut. Res. 2016, 23, 24601–24613. [Google Scholar] [CrossRef]
- Thoppil, Y.; Zein, S.H. Techno-Economic Analysis and Feasibility of Industrial-Scale Biodiesel Production from Spent Coffee Grounds. J. Clean. Prod. 2021, 307, 127113. [Google Scholar] [CrossRef]
- Zdanowicz, M.; Rokosa, M.; Pieczykolan, M.; Antosik, A.K.; Chudecka, J.; Mikiciuk, M. Study on Physicochemical Properties of Biocomposite Films with Spent Coffee Grounds as a Filler and Their Influence on Physiological State of Growing Plants. Int. J. Mol. Sci. 2023, 24, 7864. [Google Scholar] [CrossRef]
- Coelho, G.O.; Batista, M.J.A.; Ávila, A.F.; Franca, A.S.; Oliveira, L.S. Development and Characterization of Biopolymeric Films of Galactomannans Recovered from Spent Coffee Grounds. J. Food Eng. 2020, 289, 110083. [Google Scholar] [CrossRef]
- Saberian, M.; Li, J.; Donnoli, A.; Bonderenko, E.; Oliva, P.; Gill, B.; Lockrey, S.; Siddique, R. Recycling of Spent Coffee Grounds in Construction Materials: A Review. J. Clean. Prod. 2021, 289, 125837. [Google Scholar] [CrossRef]
- Kuété, M.A.; Velthem, P.V.; Ballout, W.; Klavzer, N.; Nysten, B.; Ndikontar, M.K.; Pardoen, T.; Bailly, C. Eco-Friendly Blends of Recycled PET Copolymers with PLLA and Their Composites with Chopped Flax Fibres. Polymers 2023, 15, 3004. [Google Scholar] [CrossRef] [PubMed]
- Gigante, V.; Seggiani, M.; Cinelli, P.; Signori, F.; Vania, A.; Navarini, L.; Amato, G.; Lazzeri, A. Utilization of Coffee Silverskin in the Production of Poly(3-Hydroxybutyrate-Co-3-Hydroxyvalerate) Biopolymer-Based Thermoplastic Biocomposites for Food Contact Applications. Compos. Part A Appl. Sci. Manuf. 2021, 140, 106172. [Google Scholar] [CrossRef]
- Zarrinbakhsh, N.; Wang, T.; Rodriguez-Uribe, A.; Misra, M.; Mohanty, A.K. Characterization of wastes and coproducts from the coffee industry for composite material production. Bioresources 2016, 11, 7637–7653. [Google Scholar] [CrossRef]
- Ghozali, M.; Meliana, Y.; Fatriasari, W.; Antov, P.; Chalid, M. Preparation and Characterization of Thermoplastic Starch from Sugar Palm (Arenga pinnata) by Extrusion Method. J. Renew. Mater. 2023, 11, 1963–1976. [Google Scholar] [CrossRef]
- Rosa, D.S.; Bardi, M.A.G.; Machado, L.D.B.; Dias, D.B.; Silva, L.G.A.; Kodama, Y. Starch Plasticized with Glycerol from Biodiesel and Polypropylene Blends. J. Therm. Anal. Calorim. 2010, 102, 181–186. [Google Scholar] [CrossRef]
- Cao, L.; Liu, W.; Wang, L. Developing a Green and Edible Film from Cassia Gum: The Effects of Glycerol and Sorbitol. J. Clean. Prod. 2018, 175, 276–282. [Google Scholar] [CrossRef]
- Huneault, M.A.; Li, H. Morphology and Properties of Compatibilized Polylactide/Thermoplastic Starch Blends. Polymer 2007, 48, 270–280. [Google Scholar] [CrossRef]
- ASTM E2412-10; Standard Practice for Condition Monitoring of In-Service Lubricants by Trend Analysis Using Fourier Transform Infrared (FT-IR) Spectrometry. American Society for Testing Material: West Conshohocken, PA, USA, 2018.
- ASTM E1131-20; Standard Test Method for Compositional Analysis by Thermogravimetry. American Standard and Testing Material: West Conshohocken, PA, USA, 2020.
- ASTM E96; Standard Test Methods for Water Vapor Transmission of Materials. American Society for Testing and Material: West Conshohocken, PA, USA, 2017.
- ASTM D882-12; 2012 Standard Test Method for Tensile Properties of Thin Plastic Sheeting. American Standard and Testing Material: West Conshohocken, PA, USA, 2012.
- ASTM G21-15; Standard Practice for Determining Resistance of Synthetic Polymeric Materials to Fungi. American Standard and Testing Material: West Conshohocken, PA, USA, 2021.
- Nandiyanto, A.B.D.; Ragadhita, R.; Fiandini, M. Interpretation of Fourier Transform Infrared Spectra (FTIR): A Practical Approach in the Polymer/Plastic Thermal Decomposition. Indones. J. Sci. Technol. 2023, 8, 113–126. [Google Scholar] [CrossRef]
- Zdanowicz, M. Influence of Urea Content in Deep Eutectic Solvents on Thermoplastic Starch Films’ Properties. Appl. Sci. 2023, 13, 1383. [Google Scholar] [CrossRef]
- Xu, F.; Yu, J.; Tesso, T.; Dowell, F.; Wang, D. Qualitative and Quantitative Analysis of Lignocellulosic Biomass Using Infrared Techniques: A Mini-Review. Appl. Energy 2013, 104, 801–809. [Google Scholar] [CrossRef]
- Chieng, B.W.; Ibrahim, N.A.; Yunus, W.M.Z.W.; Hussein, M.Z. Poly(Lactic Acid)/Poly(Ethylene Glycol) Polymer Nanocomposites: Effects of Graphene Nanoplatelets. Polymers 2014, 6, 93–104. [Google Scholar] [CrossRef]
- Hadjiivanov, K. Identification and Characterization of Surface Hydroxyl Groups by Infrared Spectroscopy. In Advances in Catalysis; Academic Press Inc.: Cambridge, MA, USA, 2014; Volume 57, pp. 99–318. [Google Scholar]
- Carrier, M.; Loppinet-Serani, A.; Denux, D.; Lasnier, J.M.; Ham-Pichavant, F.; Cansell, F.; Aymonier, C. Thermogravimetric Analysis as a New Method to Determine the Lignocellulosic Composition of Biomass. Biomass Bioenergy 2011, 35, 298–307. [Google Scholar] [CrossRef]
- Marcilla, A.; Berenguer, D. TGA/FTIR Study of the Decomposition of Heet Tobacco in Presence of Zeolites and Silicate Compounds. Mater. Sci. Eng. B 2023, 295, 116593. [Google Scholar] [CrossRef]
- Oluwasina, O.O.; Olaleye, F.K.; Olusegun, S.J.; Oluwasina, O.O.; Mohallem, N.D.S. Influence of Oxidized Starch on Physicomechanical, Thermal Properties, and Atomic Force Micrographs of Cassava Starch Bioplastic Film. Int. J. Biol. Macromol. 2019, 135, 282–293. [Google Scholar] [CrossRef]
- Pantani, R.; Turng, L.S. Manufacturing of Advanced Biodegradable Polymeric Components. J. Appl. Polym. Sci. 2015, 132. [Google Scholar] [CrossRef]
- Yang, Z.; Li, X.; Si, J.; Cui, Z.; Peng, K. Morphological, Mechanical and Thermal Properties of Poly(Lactic Acid) (PLA)/Cellulose Nanofibrils (CNF) Composites Nanofiber for Tissue Engineering. J. Wuhan Univ. Technol. Mater. Sci. Ed. 2019, 34, 207–215. [Google Scholar] [CrossRef]
- Morales, J.; Michell, R.M.; Sommer-Márquez, A.; Rodrigue, D. Effect of Biobased SiO2 on the Morphological, Thermal, Mechanical, Rheological, and Permeability Properties of PLLA/PEG/SiO2 Biocomposites. J. Compos. Sci. 2023, 7, 150. [Google Scholar] [CrossRef]
- Song, Z.; Xiao, H.; Zhao, Y. Hydrophobic-Modified Nano-Cellulose Fiber/PLA Biodegradable Composites for Lowering Water Vapor Transmission Rate (WVTR) of Paper. Carbohydr. Polym. 2014, 111, 442–448. [Google Scholar] [CrossRef] [PubMed]
- Long, J.; Zhang, W.; Zhao, M.; Ruan, C.-Q. The Reduce of Water Vapor Permeability of Polysaccharide-Based Films in Food Packaging: A Comprehensive Review. Carbohydr. Polym. 2023, 321, 121267. [Google Scholar] [CrossRef] [PubMed]
- Jarvis, K.L.; Evans, P.J.; Cooling, N.A.; Vaughan, B.; Habsuda, J.; Belcher, W.J.; Bilen, C.; Griffiths, G.; Dastoor, P.C.; Triani, G. Comparing Three Techniques to Determine the Water Vapour Transmission Rates of Polymers and Barrier Films. Surf. Interfaces 2017, 9, 182–188. [Google Scholar] [CrossRef]
- Massijaya, S.Y.; B Laksana, R.P.; Nissa, R.C.; Nurhamiyah, Y.; Irmayanti, M.; Ningrum, R.S.; Kusumah, S.S.; Karlinasari, L. Characterization of PLA-Based Biopolymer Composite Physical Properties with Addition of Sucrose. In Proceedings of the International Conference on Biomass and Bioenergy 2023, Bogor, Indonesia, 7–8 August 2023. [Google Scholar]
- Bertuzzi, M.A.; Castro Vidaurre, E.F.; Armada, M.; Gottifredi, J.C. Water Vapor Permeability of Edible Starch Based Films. J. Food Eng. 2007, 80, 972–978. [Google Scholar] [CrossRef]
- Ozyhar, T.; Baradel, F.; Zoppe, J. Effect of Functional Mineral Additive on Processability and Material Properties of Wood-Fiber Reinforced Poly(Lactic Acid) (PLA) Composites. Compos. Part A Appl. Sci. Manuf. 2020, 132, 105827. [Google Scholar] [CrossRef]
- Kowser, M.A.; Hossain, S.M.K.; Amin, M.R.; Chowdhury, M.A.; Hossain, N.; Madkhali, O.; Rahman, M.R.; Chani, M.T.S.; Asiri, A.M.; Uddin, J.; et al. Development and Characterization of Bioplastic Synthesized from Ginger and Green Tea for Packaging Applications. J. Compos. Sci. 2023, 7, 107. [Google Scholar] [CrossRef]
- Sofiah, Y.; Aznury, M. Melianti Mechanical Properties of Bioplastics Product from Musa Paradisica Formatypica Concentrate with Plasticizer Variables. J. Phys. Conf. Ser. 2019, 1167, 012048. [Google Scholar] [CrossRef]
- Ginting, M.H.S.; Lubis, M.; Sidabutar, T.; Sirait, T.P. The Effect of Increasing Chitosan on the Characteristics of Bioplastic from Starch Talas (Colocasia Esculenta) Using Plasticizer Sorbitol. In IOP Conference Series: Earth and Environmental Science; Institute of Physics Publishing: Bristol, UK, 2018; Volume 126. [Google Scholar]
- Zhao, X.; Liu, J.; Li, J.; Liang, X.; Zhou, W.; Peng, S. Strategies and Techniques for Improving Heat Resistance and Mechanical Performances of Poly(Lactic Acid) (PLA) Biodegradable Materials. Int. J. Biol. Macromol. 2022, 218, 115–134. [Google Scholar] [CrossRef]
- Ma, X.; Chang, P.R.; Yang, J.; Yu, J. Preparation and Properties of Glycerol Plasticized-Pea Starch/Zinc Oxide-Starch Bionanocomposites. Carbohydr. Polym. 2009, 75, 472–478. [Google Scholar] [CrossRef]
- Ballesteros, L.F.; Teixeira, J.A.; Mussatto, S.I. Chemical, Functional, and Structural Properties of Spent Coffee Grounds and Coffee Silverskin. Food Bioprocess Technol. 2014, 7, 3493–3503. [Google Scholar] [CrossRef]
- Singh, T.; Pattnaik, P.; Kumar, S.R.; Fekete, G.; Dogossy, G.; Lendvai, L. Optimization on Physicomechanical and Wear Properties of Wood Waste Filled Poly(Lactic Acid) Biocomposites Using Integrated Entropy-Simple Additive Weighting Approach. S. Afr. J. Chem. Eng. 2022, 41, 193–202. [Google Scholar] [CrossRef]
- Guerrero, P.; Garrido, T.; Leceta, I.; de la Caba, K. Films Based on Proteins and Polysaccharides: Preparation and Physical–Chemical Characterization. Eur. Polym. J. 2013, 49, 3713–3721. [Google Scholar] [CrossRef]
- Cataldo, V.A.; Cavallaro, G.; Lazzara, G.; Milioto, S.; Parisi, F. Coffee Grounds as Filler for Pectin: Green Composites with Competitive Performances Dependent on the UV Irradiation. Carbohydr. Polym. 2017, 170, 198–205. [Google Scholar] [CrossRef] [PubMed]
- Abelti, A.L.; Teka, T.A. Development and Characterization of Biodegradable Polymers for Fish Packaging Applications. J. Packag. Technol. Res. 2022, 6, 149–166. [Google Scholar] [CrossRef]
- Huang, S.; Li, H.; Jiang, S.; Chen, X.; An, L. Crystal Structure and Morphology Influenced by Shear Effect of Poly(l-Lactide) and Its Melting Behavior Revealed by WAXD, DSC and In-Situ POM. Polymer 2011, 52, 3478–3487. [Google Scholar] [CrossRef]
- Rilda, Y.; Valeri, A.; Syukri, S.; Agustien, A.; Pardi, H.; Sofyan, N. Biosynthesis, Characterization, and Antibacterial Activity of Ti-Doped ZnO (Ti/ZnO) Using Mediated Aspergillus Niger. S. Afr. J. Chem. Eng. 2023, 45, 10–19. [Google Scholar] [CrossRef]
- Nissa, R.C.; Fikriyyah, A.K.; Abdullah, A.H.D.; Pudjiraharti, S. Preliminary Study of Biodegradability of Starch-Based Bioplastics Using ASTM G21-70, Dip-Hanging, and Soil Burial Test Methods. In IOP Conference Series: Earth and Environmental Science; Institute of Physics Publishing: Bristol, UK, 2019; Volume 277. [Google Scholar]







| Blending Stage | Sample Name | Material |
|---|---|---|
| First | TPS | Starch/glycerol/sucrose (63%/34%/3%) |
| Second | PLA-TPS | PLA/TPS (60%/40%) |
| Third | SPT-5% | SCG/PLA-TPS (5%/95%) |
| SPT-10% | SCG/PLA-TPS (10%/90%) | |
| SPT-15% | SCG/PLA-TPS (15%/85%) |
| Sample | Degree of Crystallinity (%) |
|---|---|
| PLA-TPS | 6.44 |
| SPT-5% | 6.20 |
| SPT-10% | 6.87 |
| SPT-15% | 6.94 |
| Sample | Density |
|---|---|
| PLA-TPS | 0.11569523 |
| SPT-5% | 0.111961668 |
| SPT-10% | 0.09486027 |
| SPT-15% | 0.077971829 |
| Sample | 0 Day | 14 Day |
|---|---|---|
| PLA |  |  |
| 0% | 0% | |
| PLA-TPS |  |  |
| 0% | 68.85% | |
| SPT-5% |  | |
| 0% | 57.56% | |
| SPT-10% |  |  |
| 0% | 69.53% | |
| SPT-15% |  |  |
| 0% | 72.3% |
Disclaimer/Publisher’s Note: The statements, opinions and data contained in all publications are solely those of the individual author(s) and contributor(s) and not of MDPI and/or the editor(s). MDPI and/or the editor(s) disclaim responsibility for any injury to people or property resulting from any ideas, methods, instructions or products referred to in the content. |
© 2023 by the authors. Licensee MDPI, Basel, Switzerland. This article is an open access article distributed under the terms and conditions of the Creative Commons Attribution (CC BY) license (https://creativecommons.org/licenses/by/4.0/).
Share and Cite
Masssijaya, S.Y.; Lubis, M.A.R.; Nissa, R.C.; Nurhamiyah, Y.; Nugroho, P.; Antov, P.; Lee, S.-H.; Papadopoulos, A.N.; Kusumah, S.S.; Karlinasari, L. Utilization of Spent Coffee Grounds as a Sustainable Resource for the Synthesis of Bioplastic Composites with Polylactic Acid, Starch, and Sucrose. J. Compos. Sci. 2023, 7, 512. https://doi.org/10.3390/jcs7120512
Masssijaya SY, Lubis MAR, Nissa RC, Nurhamiyah Y, Nugroho P, Antov P, Lee S-H, Papadopoulos AN, Kusumah SS, Karlinasari L. Utilization of Spent Coffee Grounds as a Sustainable Resource for the Synthesis of Bioplastic Composites with Polylactic Acid, Starch, and Sucrose. Journal of Composites Science. 2023; 7(12):512. https://doi.org/10.3390/jcs7120512
Chicago/Turabian StyleMasssijaya, Sri Yustikasari, Muhammad Adly Rahandi Lubis, Rossy Choerun Nissa, Yeyen Nurhamiyah, Pramono Nugroho, Petar Antov, Seng-Hua Lee, Antonios N. Papadopoulos, Sukma Surya Kusumah, and Lina Karlinasari. 2023. "Utilization of Spent Coffee Grounds as a Sustainable Resource for the Synthesis of Bioplastic Composites with Polylactic Acid, Starch, and Sucrose" Journal of Composites Science 7, no. 12: 512. https://doi.org/10.3390/jcs7120512










